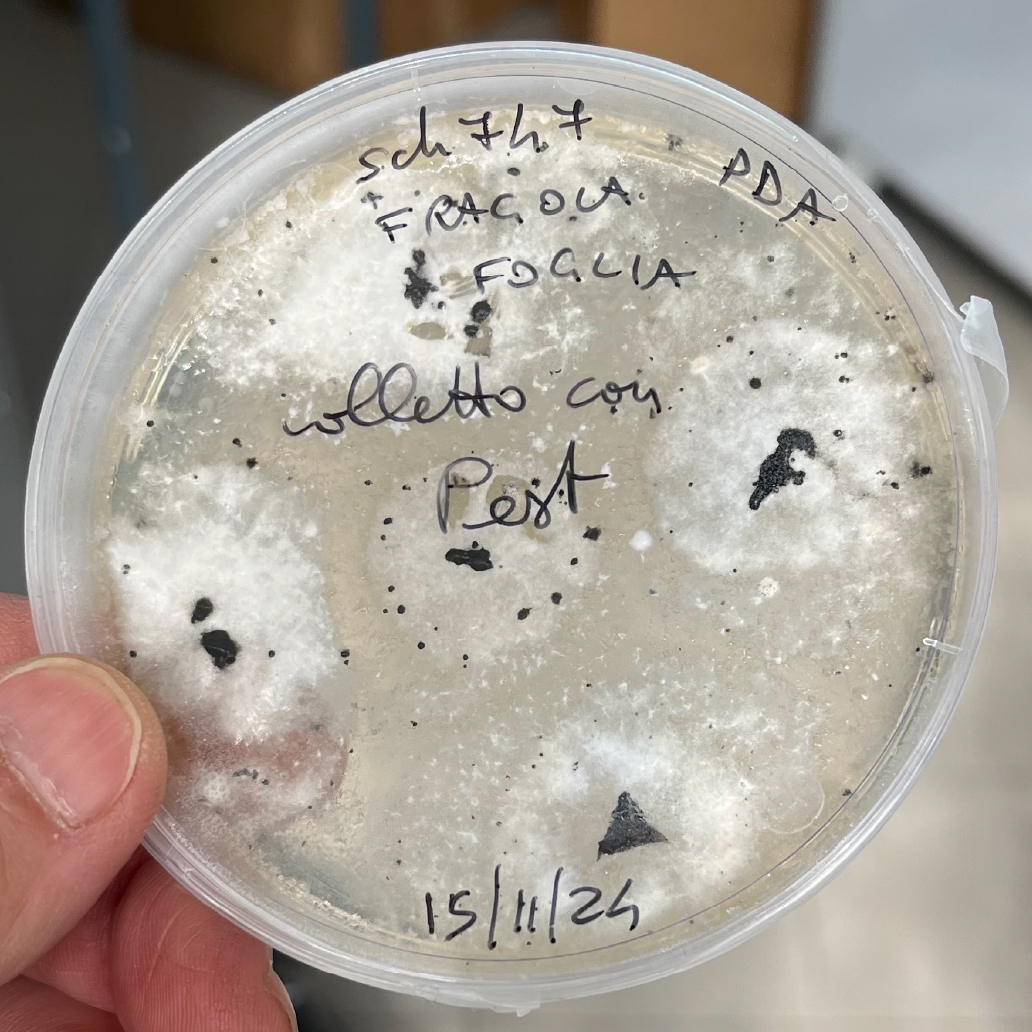

Danilo Bernardini, la mia storia dal 1985
Inizia ad occuparsi e ad appassionarsi alla fragola, in particolare all’ibridazione, al vivaismo e alla coltivazione.
Attualmente è breeder presso Berrylab, co-amministratore di New Fruits e consulente tecnico-commerciale.

Il mio menù: varietà unifere
Il mio menù: varietà rifiorenti

Il vivaio di fragola
Da 40 anni coltivo una vera passione per il mondo della fragola dedicandomi anche al settore del vivaio e alla produzione di piante di qualità.
Oggi la gamma di piante disponibili per gli agricoltori è molto più ampia rispetto al passato.

Scegliere una pianta sana, proveniente esclusivamente da vivai specializzati e conformi alle norme fitosanitarie italiane ed europee, oltre che alla regolamentazione sui brevetti vegetali, è il primo passo fondamentale verso un impianto di successo e una produzione di frutti eccellenti.
Attualmente, i vivai con cui sono collegato, offrono questa gamma di differenti tipi di piantine: Piante Frigoconservate, Cime radicate, Piante fresche a radice nuda, Minitray, Tray plants, Cime frigoconservate (winterplugs/moduli) e Apici freschi da radicare.

Piante frigoconservate

Piante frigoconservate

Piante frigoconservate

Piante frigoconservate

IBRIDAZIONE (BREEDING)
Dal 1985, grazie a una borsa di studio privata, ho scoperto una vera passione per l’ibridazione della fragola e per la ricerca e creazione di nuove varietà.
Il miglioramento genetico della fragola,
conosciuto anche come breeding o ibridazione, è un processo molto più complesso di quanto possa sembrare. Il nostro metodo si basa su tecniche tradizionali, come l’incrocio e le successive selezioni massali; richiede tempo, dedizione e un progetto solido.
Per ottenere una sola varietà competitiva o interessante, servono in media circa dieci anni di lavoro e una base di partenza di oltre 10.000 semenzali ottenuti da incrocio.









ASPARAGO
Mi dedico da sempre con passione anche al mondo degli asparagi, in particolare al settore vivaio e produzione di piante di qualità.
Nel corso degli anni, ho concentrato il mio impegno anche sulla conservazione e salvaguardia di due varietà rare e non ibride, ma dal sapore straordinario: il “Violetto di Albenga” e l’asparago selvatico “Amaro Montina”.
Tra le varietà ibride la mia preferita è l’italiana EROS, ideale per la produzione di un asparago verde, varietà molto affidabile, produttiva e molto richiesta.





Strawberry news informa
Il cambiamento climatico e la riduzione dei prodotti chimici impiegati nella difesa della fragola, a favore di pratiche più sostenibili, hanno favorito la comparsa o il ritorno di diversi patogeni, soprattutto funghi che avendo sintomi simili sono difficili da distinguere. A seguire alcuni nuovi o vecchi preoccupanti patogeni della fragola.
I funghi si possono classificare a seconda della loro comparsa in questi modi:
Parassiti Funghi che vivono a spese della pianta, sottraendo nutrienti e causando danni anche gravi, fino alla morte. Provocano malattie come muffe, marciumi, ruggini e necrosi.
Saprofiti Funghi che si nutrono di materia organica morta; in genere risultano poco dannosi.
Polifagi Funghi parassiti capaci di attaccare molte specie diverse di piante, non specializzati su un solo ospite.
Opportunisti Funghi che non attaccano piante sane, ma sfruttano condizioni favorevoli come debolezza, stress (siccità, ferite, carenze), ambienti molto umidi e caldi o danni causati da altri patogeni (es. Alternaria, Botrytis, Fusarium).
Cosmopoliti Funghi diffusi in tutto il mondo.
Ubiquitari Funghi capaci di crescere ovunque.

Agente causale Colletotrichum spp. (C. acutatum, C. gloeosporioides).
Nome comune Antracnosi della fragola.
Ospiti colpiti Fragola e molte altre specie da frutto (pomacee, drupacee, uva, agrumi, mango, noce).
Parte colpita Foglie, stoloni, frutti.
Sintomi Macchie scure sui frutti con muffa arancione; lesioni scure sugli stoloni; macchie marroni sulle foglie.
Condizioni favorevoli Umidità elevata, aspersione, piante stressate, caldo (20–28 °C).
Diffusione Acqua, attrezzi contaminati, calpestio, contatto tra piante.
Prevenzione e gestione Eliminare residui infetti, migliorare aerazione / drenaggio, usare piante certificate, evitare bagnatura fogliare, applicare fungicidi specifici e rameici, fare rotazioni colturali.




Agente causale Neopestalotiopsis rosae, Neopestalotiopsis spp, Pestalozzia phaseoli, Pestalotiopsis longisetula.
Nome comune Maculatura/Marciume secco da Pestalozzia.
Ospiti colpiti Fragola, agrumi, mango e molte specie tropicali.
Parte colpita Foglie, stoloni, frutti e talvolta la corona.
Sintomi Lesioni secche e scure sui frutti; macchie fogliari che possono portare a caduta foglie e deperimento per marciume di corona e radici.
Condizioni favorevoli Umidità elevata, piogge/aspersione, piante stressate o lesionate.
Modalità di diffusione Acqua, vento, attrezzi e terriccio contaminati.
Sopravvivenza Resta a lungo in residui vegetali e nei terreni.
Prevenzione e gestione Rimozione residui, buona aerazione e drenaggio, piante certificate, evitare bagnatura fogliare, uso di fungicidi specifici, rameici e prodotti biologici (Bacillus, Trichoderma).





Agente causale Macrophomina phaseolina.
Nome comune Marciume carbonioso / Charcoal rot.
Ospiti colpiti Fungo polifago e cosmopolita, colpisce la fragola e oltre 500 specie (solanacee, cucurbitacee, leguminose). Presente nel suolo e nei tessuti vegetali.
Parte colpita Foglie, corona, radici.
Sintomi Avvizzimento e ingiallimento fogliare; radici e corona scure. Presenza di microsclerozi neri (“carbone”). Arresto della crescita e possibili mortalità in condizioni di caldo e siccità.
Condizioni favorevoli Terreni caldi e secchi; fungo persistente nel terreno grazie ai microsclerozi. Temperature ottimali: 28–35 °C.
Modalità di diffusione Acqua, attrezzi non puliti, calpestio e contatto tra piante.
Prevenzione e gestione Eliminare residui, migliorare drenaggio e ridurre stress idrico, usare piante sane, trattamenti con fungicidi o prodotti biologici (Trichoderma, Bacillus), rameici, rotazioni e disinfezione del suolo.




I miei numeri
di esperienza
nel settore
di nostra varietà
in cui distribuiamo
i nostri prodotti































